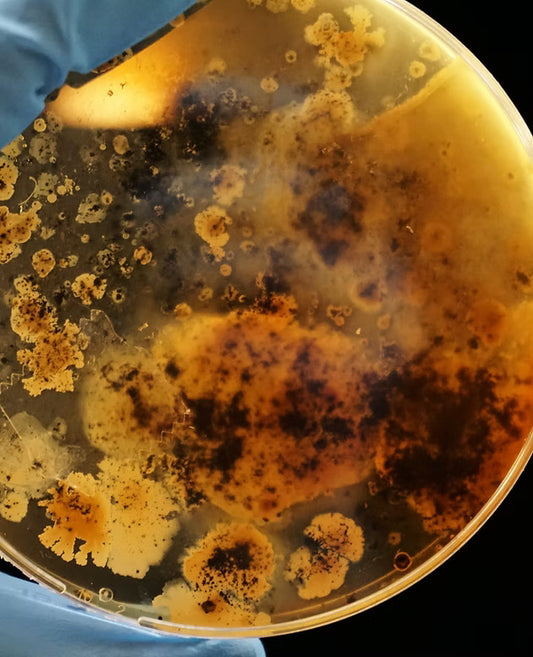

100% Transparent Label
Pineapple Bioenzymes
Himalayan Soapnuts
Pure Essential Oils
Natural yet Effective
100% Transparent Label
Pineapple Bioenzymes
Himalayan Soapnuts
Pure Essential Oils
Natural yet Effective
Our Vision
Driven to counter the chemical chaos of modern cleaning,
Forest Lab is on a mission to heal our homes as well as our planet.
Natural | Effective | Lab tested
Blog
What Really Happens Inside a Bioenzyme Bottle ?
What Your Daily Products Are Doing to your Breast Cells ?
From Toxic to Natural: A 21-Day Cleaning Reset
Real Product, Real Stories
FAQ
We use 100% naturally derived ingredients in all our formulations. Every ingredient is clearly listed on the product label and on the product page on our website. We believe in complete ingredient transparency — no hidden chemicals, no misleading claims.
The base of our product is bioenzyme, made by fermenting pineapple — a process similar to making vinegar or wine. That means it is naturally self-preserving. However, for regulatory and documentation purposes, we mention a shelf life of 2 years. When stored properly, it remains effective well beyond that.
We use only 100% pure essential oils, extracted through traditional distillation methods. You won’t find any synthetic fragrances or chemically derived "natural" scents in our products. This ensures a gentle, plant-based aroma without the risks associated with artificial fragrance compounds.
Yes, but not in the way chemical cleaners do. Our key ingredient is soap nuts, which have natural foaming properties. However, they need to be hydrated and slightly agitated to produce foam. The foam generated is just the right amount needed for cleaning, not for show.
Unlike synthetic foaming agents like SLS or SLES, which are designed to create excessive foam to appeal to your psychology, our foam is functional. You don’t need a mountain of foam to clean effectively — that’s just marketing. What you get here is real cleaning, not a bubble show.
- Choosing a selection results in a full page refresh.